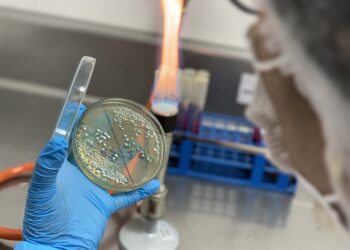

Somos la revista del sector pesquero más importante del Perú, con distribución en Ecuador. Nuestros esfuerzos están enfocados en la publicación de temas relacionados al sector pesquero y ambiental a nivel mundial. Nuestras líneas de investigación son realizadas por un staff de periodistas de reconocida trayectoria en el área ambiental y social de Latinoamérica.
Menú principal
Menu
Suscripción
¡Suscríbase a nuestra lista de correo para recibir actualizaciones diarias directamente en su bandeja de entrada!